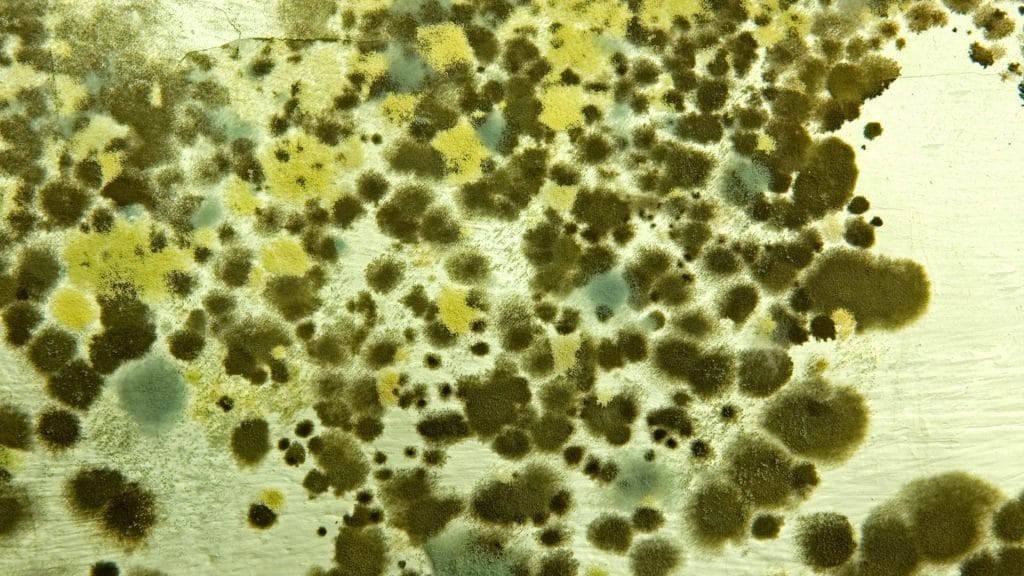

The Mould Lifecycle: Why Southeast Asia’s Climate is a Breeding Ground
Key Takeaways
- Tropical climates presents ongoing challenges for managing indoor biological growth, as high humidity and frequent rainfall create the right environment for mould to grow on commercial properties.
- Multiple environmental factors must be addressed together to prevent recurring issues, including moisture control, ventilation improvements, and to apply anti-mould paint and use materials which are less hygroscopic.
- Once mould growth takes hold, it spreads easily through air circulation systems and onto porous materials, often going unnoticed until it becomes widespread.
- Effective long-term control requires more than surface cleaning; it relies on comprehensive environmental management and professional remediation to prevent repeated damage.
Introduction
In Asia’s tropical climate, the presence of mould is a persistent concern for commercial and industrial properties. Consistently high humidity, regular rainfall, and temperature differences between indoor and outdoor environments create conditions that favour rapid mould development. Once established, mould can spread quickly, affecting indoor air quality, degrading building materials, and increasing health and safety risks.
For businesses, particularly those managing facilities after water-related incidents, understanding the mould life cycle is critical. Mould growth is rarely caused by a single factor. More often, it results from a combination of environmental conditions, including excess moisture, insufficient airflow, limited sunlight, and the presence of porous materials that support spore settlement. Even after cleaning, these conditions can lead to recurring outbreaks if not comprehensively addressed.
This article outlines the typical progression of mould in Southeast Asian environments and highlights key measures that can help businesses reduce long-term exposure and damage.
Moisture Triggers Rapid Mould Growth in Just One to Two Days
Malaysia’s consistently high humidity creates ideal conditions for mould to develop and spread. Mould requires at least 60 percent relative humidity to thrive. With Malaysia’s average relative humidity hovering around 80 percent, for example, surfaces remain consistently susceptible to moisture retention. When dampness is present, airborne spores can settle and begin germinating within 12 to 24 hours. Even minor leaks, condensation from air-conditioning systems, or insufficient ventilation can trigger the onset of mould growth.
Typical areas of concern include spaces behind cabinets, under sinks, inside closets, and near cooling units. Once growth begins, the mould life cycle advances quickly, releasing new spores into the air and increasing the risk of widespread contamination throughout the property.
Why Are Spores So Persistent Even After Cleaning?
Mould spores are always present in the air, even when no visible growth is detected. They settle easily on porous materials such as drywall, wood, fabric, and paper, which are widely used in commercial interiors. These materials can retain spores long after the initial contamination appears to be resolved.
When conditions become favourable again, such as after a rise in humidity or a water leak, spores can become active and lead to new outbreaks. This is why a detailed indoor air quality assessment is essential following any water-related incident. It helps identify hidden contamination, assess the extent of airborne spore presence, and guide decisions on remediation before further damage occurs.

Poor Ventilation Creates Hidden Breeding Grounds
Inadequate airflow is a critical but often overlooked factor in mould development. When rooms remain closed, vents are obstructed, or air-conditioning is used inconsistently, moisture can accumulate. Over time, this leads to condensation in corners, ceilings, and behind furniture, allowing the mould life cycle to continue without detection.
Storage rooms, server areas, and infrequently used spaces are especially vulnerable. Facilities that rely on cooling systems without adequate fresh air exchange face a higher risk of hidden mould growth. In such cases, early intervention through commercial mould remediation is essential to prevent structural damage and protect indoor conditions.
Mature Mould Releases Airborne Spores That Spread Rapidly Indoors
Once mould reaches maturity, it begins releasing spores into the surrounding air. These airborne particles can travel through ventilation systems and settle on walls, ceilings, furnishings, and other surfaces throughout the building. Even areas that were previously unaffected can quickly become new sites of growth.
If a small outbreak is not contained early, the risk of widespread contamination increases significantly. In cases where more aggressive or toxic strains are present, professional black mould treatment is often necessary to eliminate the threat safely and restore safe indoor conditions.
Why Mould Regrowth Can Occur Even After Cleaning
A common challenge in mould management is its tendency to return, even after a space appears clean. Spores can remain dormant within porous materials such as wood, drywall, and insulation. When moisture reappears, due to humidity, leaks, or condensation, these spores can reactivate and begin growing again.
Surface cleaning alone is rarely sufficient. Without thorough structural drying, proper moisture control, and ongoing environmental monitoring, the mould life cycle will continue. Complete remediation is essential to eliminate residual spores and maintain a stable, contamination-free indoor environment.

Understanding Mould Is the First Step Towards Prevention
In Asia’s climate, mould is not an occasional issue but a recurring concern for many commercial properties. Persistent humidity, poor ventilation, dark spaces and water exposure make indoor environments especially vulnerable. Understanding how the mould life cycle progresses allows property managers to intervene early and implement strategies that reduce the risk of repeated outbreaks.
BELFOR works with commercial and industrial clients across Asia to manage every stage of the mould cycle, from initial site assessment to full remediation and recovery. Our team provides targeted solutions that address underlying causes and support long-term environmental stability.
If your commercial property is facing recurring mould concerns, contact BELFOR today for a professional response that protects your infrastructure, operations, and indoor environment.